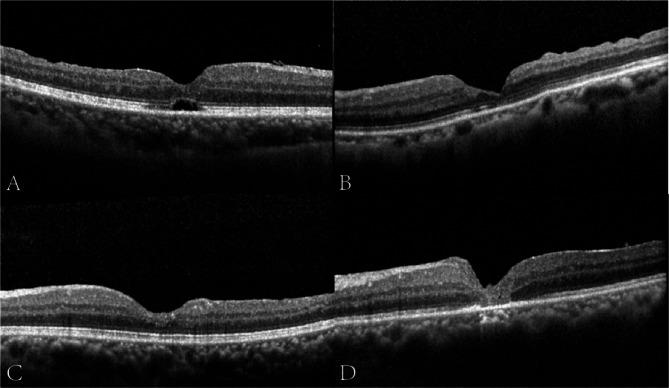
https://cdn.ncbi.nlm.nih.gov/pmc/blobs/dc2e/11978172/e1d94d6acb62/12886_2025_4003_Fig1_HTML.jpg

在大的全层黄斑裂孔手术中三步法与倒置内界膜瓣技术的比较研究
A three-step approach versus the inverted internal limiting membrane flap technique in large full thickness macular hole surgery: a comparative study.
作者信息
Lai Dongwei, Tang Siao, Gu Chufeng, Meng Chunren, Cai Chunyang, He Shuai, Qiu Qinghua
机构信息
Department of Ophthalmology, Shanghai General Hospital, Shanghai Jiao Tong University School of Medicine, Shanghai, 200336, PR China.
Department of Ophthalmology, Tong Ren Hospital, Shanghai Jiao Tong University School of Medicine, Shanghai, 200336, PR China.
出版信息
BMC Ophthalmol. 2025 Apr 8;25(1):182. doi: 10.1186/s12886-025-04003-0.
OBJECTIVE
To evaluate the anatomical and functional outcomes of our novel surgery (a three-step approach) and the conventional inverted internal limiting membrane flap technique (IFT) in treating large full-thickness macular holes (FTMHs).
METHODS
This was a retrospective, consecutive, nonrandomized comparative study of patients who underwent either the novel surgery (n = 27, Group A) or IFT (n = 27, Group B). The main outcomes of MH closure rates and the best corrected visual acuity (BCVA) at 1-, 3-, and 6-month follow-up were compared between the two groups.
RESULTS
At 6 months postoperatively, MH closure was achieved in 24/27 patients in Group A and 22/27 patients in Group B (88.89% vs. 81.48%, P = 0.704) with U-shaped closure rates being significantly higher in Group A (P = 0.029). The average BCVA at month 6 was 0.69 ± 0.38 (LogMAR) in Group A and 0.91 ± 0.39 in Group B (P = 0.015) with the improvement in BCVA being significantly higher in Group A (0.50 ± 0.59 vs. 0.31 ± 0.59, P = 0.045). The recovery rates of ELM were significantly higher in Group A (P = 0.026).
CONCLUSIONS
Our three-step approach greatly improves anatomical and functional outcomes compared with IFT. This novel surgery has a dominant advantage in earlier and higher ultimate closure rate, U-type closure rate, and ELM recovery rate, and more importantly, better recovery of BCVA.
目的
评估我们的新型手术(三步法)和传统内界膜翻转瓣技术(IFT)治疗大的全层黄斑裂孔(FTMHs)的解剖学和功能学结果。
方法
这是一项对接受新型手术(n = 27,A组)或IFT(n = 27,B组)的患者进行的回顾性、连续性、非随机对照研究。比较两组在术后1个月、3个月和6个月时黄斑裂孔闭合率和最佳矫正视力(BCVA)的主要结果。
结果
术后6个月时,A组24/27例患者黄斑裂孔闭合,B组22/27例患者黄斑裂孔闭合(88.89%对81.48%,P = 0.704),A组U形闭合率显著更高(P = 0.029)。A组6个月时平均BCVA为0.69±0.38(LogMAR),B组为0.91±0.39(P = 0.015),A组BCVA改善显著更高(0.50±0.59对0.31±0.59,P = 0.045)。A组外层限制膜(ELM)恢复率显著更高(P = 0.026)。
结论
与IFT相比,我们的三步法极大地改善了解剖学和功能学结果。这种新型手术在早期和更高的最终闭合率、U型闭合率和ELM恢复率方面具有显著优势,更重要的是,能更好地恢复BCVA。